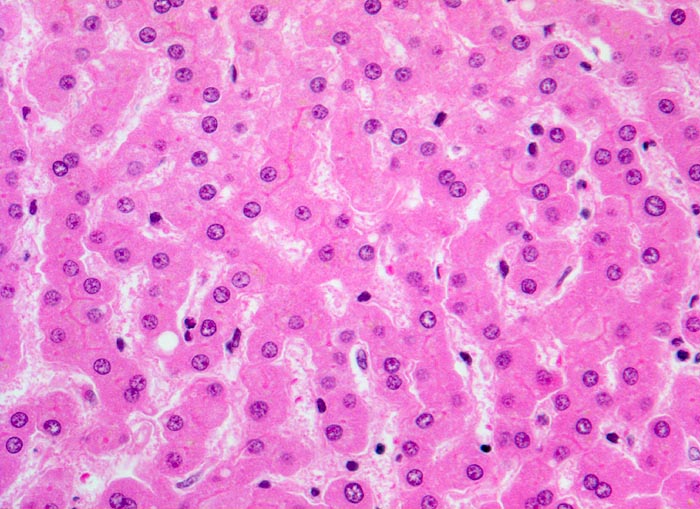

PathoPic – image database / PathoPic ID 3129 - Normales Leberparenchym
de
Diagnose
Normales Leberparenchym
Diagnose Gruppe
Normalbefund
Topographie
Leber
Topographie Gruppe
Leber, Gallenwege, Pankreas
Beschreibung
Ein- bis zweireihige Leberzellplatten. Dazwischen Sinusoide.
Bilder Typ
Histologie
Vergrösserung
200
Geschlecht
weiblich
Datum
Ersteintrag: 21.03.2002